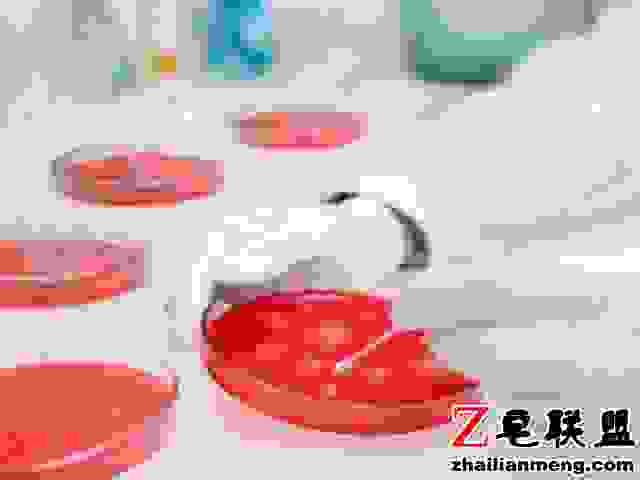

最近发现,很多备孕的男女都在咨询男子精液常规检查的问题。毕竟怀孕不是女人的私事儿,男人的精液也是决定怀孕几率的所在。所以本文为大家介绍关于精液常规检查的项目,让各位没有做过精液常规检查的准爸爸妈妈们,有个直观的了解。

精液常规检查-你要知道的事
检验项目:
1。量
一般为2-6毫升,当然,在提前一周停止住宿的前提下,如果少于1.5毫升或超过8毫升,则视为有问题。
2。颜色
肉眼能观察到的正常精液颜色是灰白色或者乳白色,长期禁欲的男人精液可能带点儿淡黄色。但如果出现其他颜色,比如黄中带绿,那就是前列腺或精囊可能会发炎。如果附件腺和后尿道呈红色,则可能发生炎症。偶尔也会发生在肺结核或癌症患者身上。
3。固化和液化
精液刚被排出时是一种粘性液体。它会在几秒钟内凝固成半透明凝胶。精液液化通常需要5到20分钟,而且液化超过一小时是有问题的。
4。气味
精液有一种特殊的鱼腥味,很难描述它的味道,而且气味是一种非常主观的东西,更不用说了。
5。粘度
使用精液粘度管(长93mm,内径0.672mm)测量液化精液。通过0.5毫升精液所需的平均时间为17秒。最简单的操作是用专业的小工具挑起精液粘丝,粘丝长度应小于2厘米。
6。pH值
通常在7.2~8.0之间,酸碱度的变化对精子的运动和代谢有一定的影响,对疾病的鉴定有一定的意义。
7。精子密度
超过1500万/毫升,精子计数低或精浆过多会降低精子密度并影响生育。
8。精子存活率
精液中活精子的比例不能少于低于58%,如果低于这个数值就惨了。






